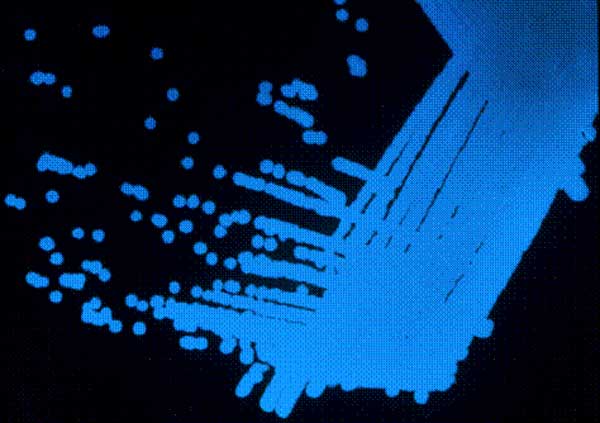

Stephanie Dutchen
Latest articles by Stephanie Dutchen

Metals: In Sickness and in Health
By Stephanie Dutchen published
Metals play key roles in human health, from ensuring healthy bones to helping make red blood cells.

A New Twist On Old Painkillers
By Stephanie Dutchen published
Researchers are looking for a way to avoid the negative side effects of pain-relieving medicines.

Why Sugars May Be the Body's Superstars
By Stephanie Dutchen, Allison MacLachlan published
You may be surprised at all the work sugars do within our cells.

After a Good Night's Sleep Brain Cells Are Ready to Learn
By Stephanie Dutchen published
Neuroscientist Chiara Cirelli at the University of Wisconsin-Madison and others believe that a good night's sleep helps us learn more the next day.

Under Pressure: Peeking in on Contracting Cells
By Stephanie Dutchen published
A microscopic stretch detector senses the pressures inside real tissues, to see how cells react.

A New Use for Census Data: Disease Simulations
By Stephanie Dutchen published
Researchers are developing disease-spread models from actual US census data
Cool Tools: Visualizing the Invisible
By Stephanie Dutchen published
National Institutes of General Medical Sciences' imaging programs are peering into the lives of cells.

Inside Life Science: What Is an Ontology?
By Stephanie Dutchen published
Virtual libraries may help biomedical researchers share ever-growing knowledge.

Cell Suicide: An Essential Part of Life
By Stephanie Dutchen, Kirstie Saltsman published
Programmed cell death serves a healthy and protective role in our bodies.

The Many Mysteries of Anesthesia
By Stephanie Dutchen published
Anesthetics have been used in many procedures for more than 150 years, doctors and scientists still don't know exactly how these medicines work in the body.
Learning from Bacterial Chatter
By Stephanie Dutchen published
What do digestion, cholera and tooth plaque have in common?
Sign up for the Live Science daily newsletter now
Get the world’s most fascinating discoveries delivered straight to your inbox.